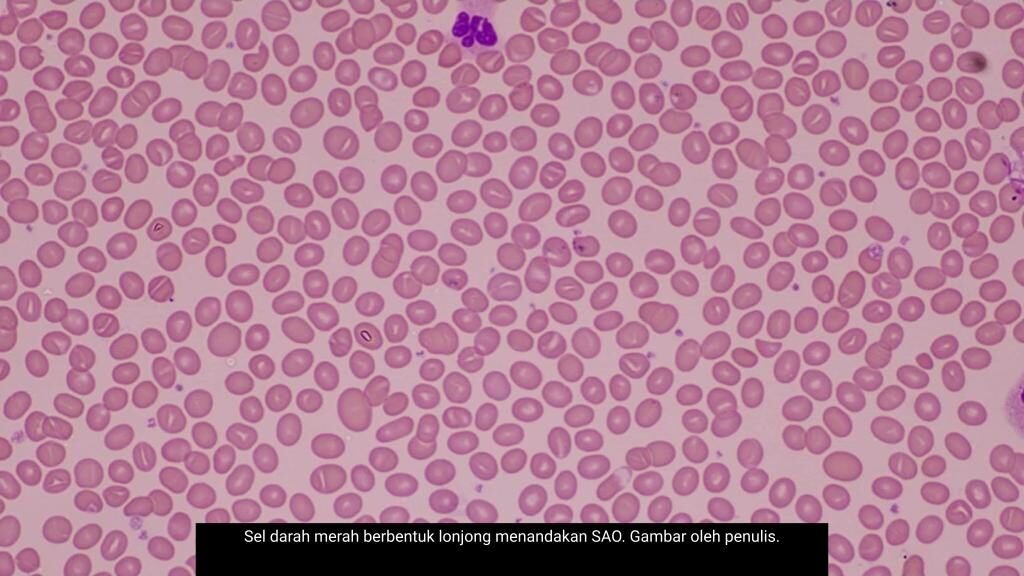
28_3

Oleh Dr. Hafizuddin Mohamed Fauzi
Pernahkah anda menjalani ujian darah dan dimaklumkan bahawa terdapat sesuatu yang “tidak normal” pada keputusan tersebut?
Bagi ramai orang, istilah seperti ini boleh menimbulkan kebimbangan. Walaupun tubuh terasa sihat dan tiada gejala yang jelas, perkataan “tidak normal” dalam laporan makmal sering membawa bayangan sesuatu yang serius. Dalam keadaan ini, tidak hairan jika seseorang terus memikirkan kemungkinan penyakit yang memerlukan rawatan segera.
Namun hakikatnya, tidak semua keputusan yang kelihatan tidak normal membawa maksud penyakit.
Salah satu contoh yang sering menimbulkan salah faham ialah *Southeast Asian Ovalocytosis* atau SAO. Namanya kedengaran teknikal dan mungkin asing bagi kebanyakan orang, tetapi keadaan ini sebenarnya bukan penyakit. Ia merupakan satu variasi genetik yang mempengaruhi bentuk sel darah merah, dan agak lazim dalam kalangan masyarakat Asia Tenggara termasuk Malaysia, Indonesia dan Thailand.
Dalam keadaan ini, sel darah merah tidak berbentuk bulat seperti biasa, tetapi lebih lonjong dan sedikit lebih keras. Perubahan ini berpunca daripada variasi pada satu protein penting di permukaan sel darah merah yang berfungsi mengekalkan bentuk dan keanjalannya. Apabila struktur protein ini berubah, sel darah merah turut berubah sifatnya. Keadaan ini boleh dikenal pasti melalui ujian darah biasa atau pemerhatian di bawah mikroskop, di mana sel-sel yang berbentuk bujur ini akan kelihatan dengan jelas.
Walaupun penjelasan ini mungkin kedengaran agak teknikal, perkara yang lebih penting untuk difahami ialah kesannya terhadap individu tersebut. Dalam kebanyakan kes, individu dengan SAO tidak mengalami sebarang gejala. Mereka tidak mudah letih, tidak pucat, dan tidak menunjukkan tanda-tanda kekurangan darah. Ramai hanya mengetahui tentang keadaan ini secara tidak sengaja apabila menjalani ujian darah atas sebab lain, seperti pemeriksaan kesihatan berkala atau sebelum sesuatu prosedur perubatan.
Menariknya, SAO dipercayai telah lama wujud dalam sejarah populasi manusia, khususnya di kawasan yang pernah terdedah kepada jangkitan malaria. Terdapat bukti bahawa variasi ini memberikan perlindungan separa terhadap jangkitan tersebut, menjadikannya satu bentuk penyesuaian biologi terhadap persekitaran pada masa lalu. Ini menunjukkan bahawa tidak semua perubahan dalam tubuh manusia bersifat merugikan. Ada yang sebenarnya membawa kelebihan dalam konteks tertentu.
Walau bagaimanapun, keadaan ini boleh menjadi lebih kompleks sekiranya ia berlaku bersama masalah kesihatan lain. Sebagai contoh, jika seseorang dengan SAO juga mengalami kekurangan zat besi atau menghidap penyakit darah warisan seperti talasemia, mereka mungkin menunjukkan gejala anemia seperti keletihan, pening atau pucat. Dalam situasi seperti ini, adalah penting untuk membezakan punca sebenar gejala tersebut, kerana SAO itu sendiri jarang menjadi penyebab utama.
Disebabkan ia bersifat keturunan, SAO boleh diwarisi daripada ibu atau bapa kepada anak. Jika hanya salah seorang ibu atau bapa merupakan pembawa, setiap kehamilan mempunyai kira-kira 50 peratus peluang untuk anak mewarisi keadaan ini. Dalam kebanyakan kes, anak yang mewarisinya akan membesar tanpa sebarang masalah kesihatan yang berkaitan. Namun jika kedua-dua ibu dan bapa adalah pembawa, terdapat kemungkinan yang lebih kecil untuk anak mewarisi bentuk yang lebih serius, yang mungkin memerlukan pemantauan rapi sejak awal kehidupan.
Semua ini membawa kepada persoalan yang lebih praktikal. Apakah yang perlu dilakukan apabila berdepan dengan laporan ujian darah yang menyatakan sesuatu yang tidak normal?
Langkah pertama ialah memahami bahawa laporan makmal hanyalah sebahagian daripada gambaran keseluruhan kesihatan seseorang. Nilai dan istilah yang tertera perlu ditafsir bersama sejarah kesihatan, pemeriksaan klinikal, dan keadaan semasa individu tersebut. Tanpa konteks ini, mudah untuk kita membuat andaian yang tidak tepat.
Selain itu, berbincang dengan doktor adalah langkah yang sangat penting. Doktor bukan sahaja akan menjelaskan maksud istilah dalam laporan tersebut, tetapi juga membantu menentukan sama ada penemuan itu mempunyai implikasi kesihatan yang signifikan atau sekadar variasi yang tidak memerlukan rawatan.
Dalam banyak keadaan, kebimbangan sebenarnya timbul bukan kerana keadaan itu berbahaya, tetapi kerana maklumat yang diterima tidak difahami sepenuhnya. Istilah perubatan yang kompleks boleh kelihatan menakutkan apabila dibaca tanpa penjelasan, walaupun maksud sebenarnya tidaklah seburuk yang disangka.
Akhirnya, SAO mengingatkan kita bahawa tidak semua yang berbeza itu perlu dianggap sebagai masalah. Dalam tubuh manusia, terdapat pelbagai variasi semula jadi yang tidak menjejaskan kehidupan seharian. Dengan kefahaman yang lebih baik, kita dapat melihat keputusan ujian dengan lebih tenang dan membuat keputusan kesihatan yang lebih bijak, tanpa dibebani kebimbangan yang tidak perlu.

Penulis merupakan Pakar Hematopatologi UD15, Jabatan Patologi dan Makmal Perubatan, Hospital UniSZA (HoSZA), Kuala Terengganu.





